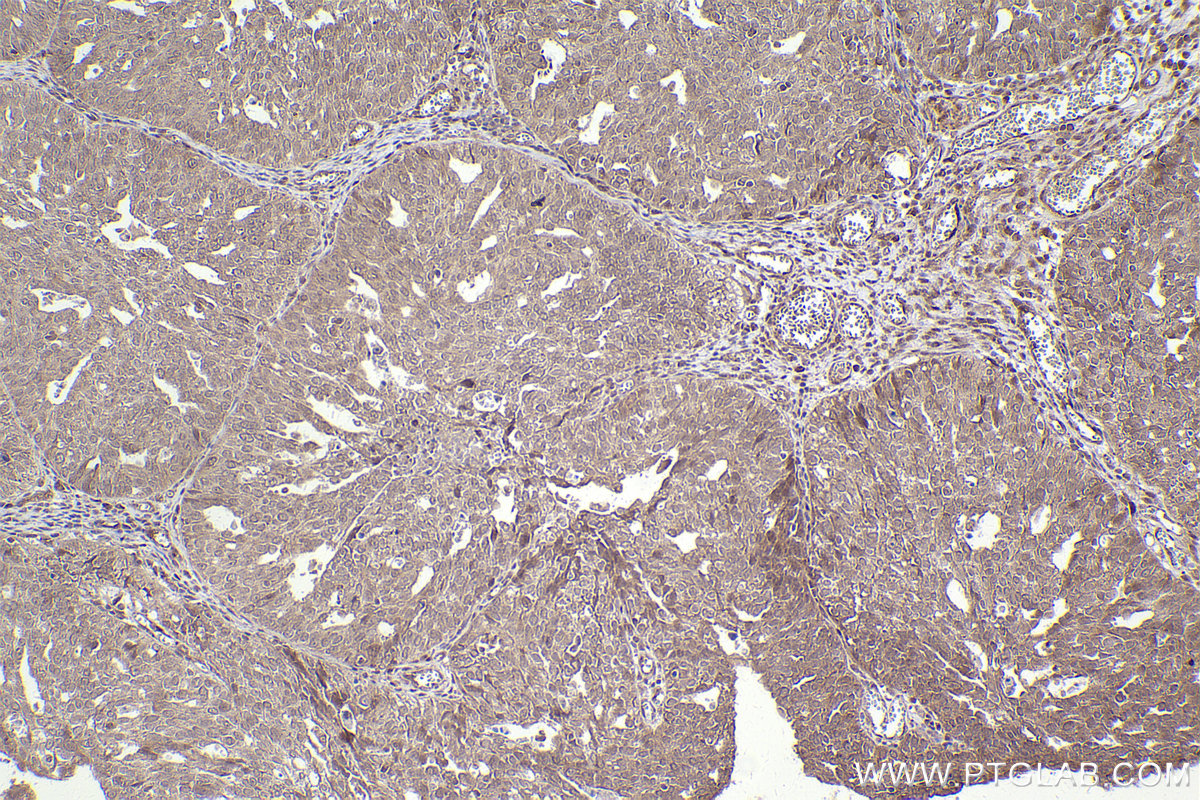
IHCeasy NFE2L2/NRF2 Ready-To-Use IHC Kit KHC2502 | Proteintech | 武汉三鹰生物 ...

Enhance your business with our remarkable commercial embedded language – gabriela löffel collection of substantial collections of professional images. optimized for commercial use with photography, images, and pictures. perfect for advertising and marketing campaigns. Discover high-resolution embedded language – gabriela löffel images optimized for various applications. Suitable for various applications including web design, social media, personal projects, and digital content creation All embedded language – gabriela löffel images are available in high resolution with professional-grade quality, optimized for both digital and print applications, and include comprehensive metadata for easy organization and usage. Our embedded language – gabriela löffel gallery offers diverse visual resources to bring your ideas to life. Multiple resolution options ensure optimal performance across different platforms and applications. Time-saving browsing features help users locate ideal embedded language – gabriela löffel images quickly. Professional licensing options accommodate both commercial and educational usage requirements. Reliable customer support ensures smooth experience throughout the embedded language – gabriela löffel selection process. Cost-effective licensing makes professional embedded language – gabriela löffel photography accessible to all budgets. The embedded language – gabriela löffel archive serves professionals, educators, and creatives across diverse industries. The embedded language – gabriela löffel collection represents years of careful curation and professional standards.













































![Lck重组抗体[EPR27974-93]_Lck抗体(ab318961)| Abcam中文官网](https://www.abcam.cn/ps/products/318/ab318961/Images/ab318961-4-anti-lck-phospho-y394-antibody-epr27974-93-immunohistochemistry-human-tonsil.jpg)
















![Lck重组抗体[EPR27974-93]_Lck抗体(ab318961)| Abcam中文官网](https://www.abcam.cn/ps/products/318/ab318961/Images/ab318961-6-anti-lck-phospho-y394-antibody-epr27974-93-immunohistochemistry-human-breast-cancer.jpg)

![Lck重组抗体[EPR27974-93]_Lck抗体(ab318961)| Abcam中文官网](https://www.abcam.cn/ps/products/318/ab318961/Images/ab318961-5-anti-lck-phospho-y394-antibody-epr27974-93-immunohistochemistry-human-spleen.jpg)












![Anti-MAP1B 抗体 [EPR27224-93] (ab315226) | アブカム](https://www.abcam.co.jp/ps/products/315/ab315226/Images/ab315226-2-anti-map1b-antibody-epr27224-93-immunohistochemistry-human-cerebrum.jpg)